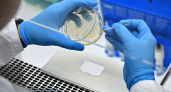
Ученые Мордовии предложили новаторский метод лечения грибковых заболеваний

Новости
Последние новости
В Мордовии дан старт отборочному этапу «Зарницы 2.0»
11:15Жители г. Саранска пожаловались на протекающую крышу в доме № 9 по ул. Семашко
10:10Студенты Мордовии - победители XI Интеллектуальной олимпиады «IQ ПФО»
09:05Жителей Мордовии предупредили о риске столкновения с животными на дорогах
ВчераЖитель Рузаевки на три года отправился в тюрьму за незаконное хранение наркотиков
ВчераВ Мордовии на контроле специалистов находится уровень воды в р. Инсар
ВчераПолицейские г. Саранска задержали участников драки на ул. Чкалова
ВчераВ Саранске активно продолжается строительство Спасского храма-часовни
ВчераВ Саранске 1 апреля стартует акция «Чистый город»
ВчераБастрыкин потребовал предоставить доклад по делу о нарушении прав жильцов дома в г. Саранске
ВчераВ Мордовии планируют открыть пять новых объектов для размещения туристов
ВчераБатыр Эмеев отметил большой потенциал мусоросортировочного комплекса в г. Саранск
ВчераВ Мордовии директор МУПа скрыл от налогового органа более 6 млн рублей
ВчераСаранск обновляет дорожную сеть: стартовал ремонт улицы Коваленко
27 мартаЛучшие умы Приволжья: в Саранске открылась XI Интеллектуальная олимпиада «IQ ПФО»
27 мартаВ Саранске на проспекте Российской Армии обнаружили открытый люк
27 мартаВ Рузаевке сгорел мусорный бак: жители говорят о поджоге
27 мартаМолодая девушка из Саранска подозревается в незаконном обороте более 860 тысяч рублей
27 мартаНе устранили за 8 лет: в Саранске торговую площадку закроют за нарушения пожарной безопасности
27 мартаНацстандарт: промышленный туризм в Мордовии получил признание "Роскачества"
27 мартаУроженка Мордовии погасила долг в 4,2 млн рублей после предупреждения об уголовном деле
27 мартаВ Мордовии чиновники заплатят компенсацию ребенку за укус бродячей собаки
27 мартаВесна показала весь мусор: жители Мордовии возмущены состоянием улиц
27 мартаЗамминистра сельского хозяйства РФ Ксения Шевёлкина в Мордовии: "Кадры решают все!"
27 мартаВ Мордовии водитель скрылся с места ДТП и был задержан
27 мартаВ Рузаевке пешеходный переход у больницы так и не расчистили после зимы
27 мартаСотрудники республиканского МВД депортировали из России пять иностранных граждан с уголовным прошлым
27 мартаПодделал документы: в Мордовии осудили 25‑летнего мужчину за крупное мошенничество с социальной выплатой
27 мартаВ Саранске у дома на Чкалова произошла драка студентов
27 мартаОвечкин разбушевался: капитан "Вашингтона" сделал хет-трик
27 мартаВ Саранске жители Химмаша вечером остались без света, воды и связи
27 мартаБывший министр культуры Мордовии Владимир Шарапов открыл творческую мастерскую
27 мартаПочти 30 процентов продукции Мордовии считается инновационной
27 мартаВ Мордовском университете имени Н.П. Огарева назвали даты "Студенческой весны-2026"
27 мартаУченые Мордовии предложили новаторский метод лечения грибковых заболеваний
27 марта


В Саранске жители Химмаша вечером остались без света, воды и связи
27 марта
Бывший министр культуры Мордовии Владимир Шарапов открыл творческую мастерскую
27 марта
Почти 30 процентов продукции Мордовии считается инновационной
27 марта
В Мордовском университете имени Н.П. Огарева назвали даты "Студенческой весны-2026"
27 марта
Ученые Мордовии предложили новаторский метод лечения грибковых заболеваний
27 марта
В Мордовии мужчина заплатил долг по алиментам после 18-летия дочери
27 марта
В Саранске начались ямочный ремонт дорог и благоустройство территорий на 1,5 млрд рублей
27 марта
Последний ветеран: в Ковылкинском районе Мордовии чествовали участника Великой Отечественной войны
27 марта
С начала года в Мордовии произошло 8 ДТП с участием детей
27 марта
Превзошел иномарки: в Мордовии протестировали самосвал КАМАЗ поколения К5
27 марта
Мордовия инициирует создание социального стандарта для сельских жителей
27 марта
В Саранске снег отрезал проход к подъездам дома на Центральной улице
26 марта
Из Мордовии в Абхазию отправилось 13 тонн кормов для домашних животных
26 марта
